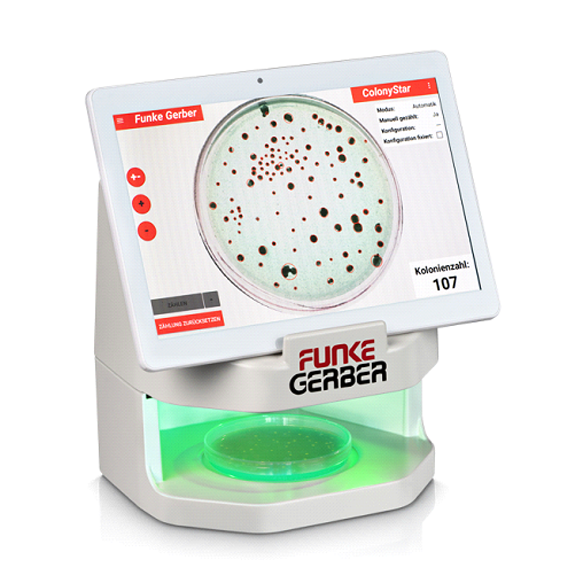
ColonyStar_automata

Manuális üzemmód a Petri-csésze egyedi kiértékelését jelenti, a kép nagyításának lehetőségével. Egy kolónia „megérintése” és jelölése az érintőképernyőn történik. A hibásan megjelölteket törli ismételt érintésre.
A félautomata üzemmódban (asszisztencia üzemmód) egy kolónia megjelölése után a többi, nem megjelölt, azonos típusú kolónia automatikusan megjelölésre kerül a méret, alak, szín, kontraszt, fényerő alapján. A hibásan megjelölt törlődik, új érintésre. Egy Perti-csésze így néhány jelölési lépés után teljesen megszámlálásra kerül.
Ha a készülék már be van programozva (megvannak megfelelően elmentett profilok), akkor teljesen automatikus üzemmódban is működtethető. Így a készülék másodpercek alatt, kézi beavatkozás nélkül képes teljesen automatikusan kiértékelni a Petri-csészéket.
LETÖLTHETŐ DOKUMENTUM: